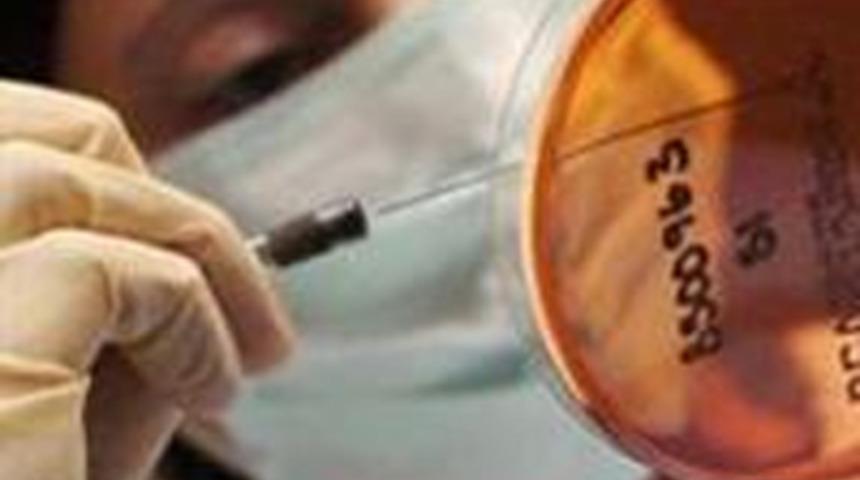
Esrarengiz hastalık &ouml;ld&uuml;r&uuml;yor

Quang Ngai vilayetindeki Ba To bölgesinin Halk Komitesi Başkanı Le Han Phong, yüksek ateş, iştah kaybı ve el ile ayaklarda kaşıntı ile başlayan hastalığa yakalanan kişilerin erken tedavi edilmemesi durumunda, karaciğerlerinde sorun yaşandığını ve sonucunda ölüme kadar giden daha fazla organın zarar gördüğünü belirtti.
Phong, hastalanan yaklaşık 100 kişinin hastaneye kaldırıldığını, bunlardan 10'unun durumunun kritik olduğunu, hafif belirtiler gösteren hastaların ise evde tedavi edildiğini kaydetti. Phong, hastalığın erken tedaviye olumlu yanıt verdiğini, ancak 29 kişinin iyileştikten sonra yeniden hastalığa yakalandığını ifade etti.
Hastalığın ilk olarak geçen yıl Nisan ayında ortaya çıktığını, ancak Ekim ayında ölüm vakalarında düşüş olduğunu belirten Phong, 27 Mart ve 5 Nisan günleri arasında 8'i ölümle sonuçlanan 68 vaka bildirildiğini kaydetti.
Sağlık Bakanlığı'nın bu ayın başında hastalığın görüldüğü bölgeye bir ekip gönderdiği, ancak ekibin hastalığın nedenini belirleyememesi üzerine, Dünya Sağlık Örgütü ve ABD Hastalık Kontrol ve Önleme Merkezi'nden yardım istendiği kaydedildi.